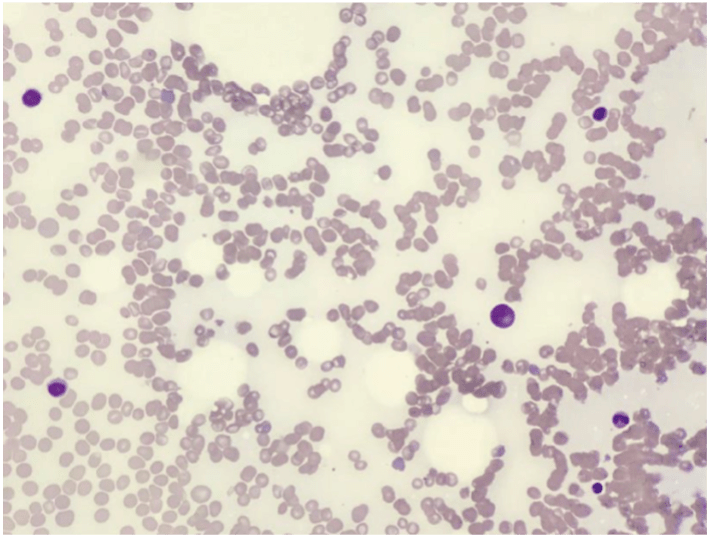
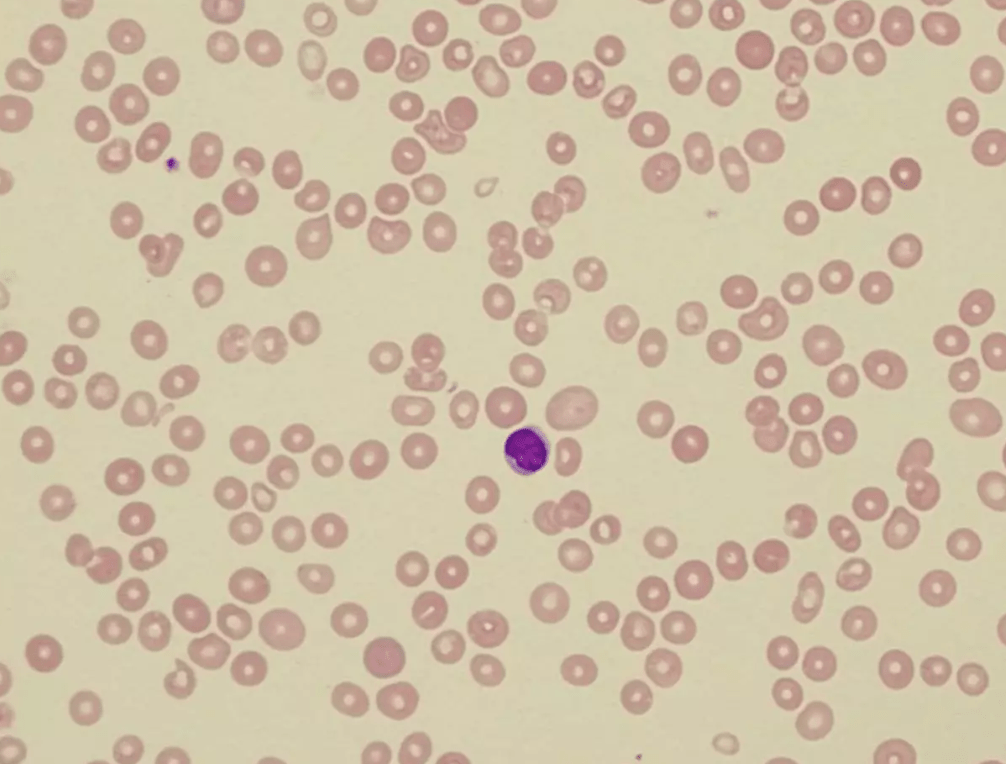

Encik Shamshul, a 24-year old man presents with complaints of progressive weakness and shortness of breath with minimal physical effort over the last two weeks. He also notes recurrent episodes of fever requiring repeated visits to his local general practitioner over the past couple of months.
History
Shamshul reports that his symptoms have been progressive over the past 2 months and seems especially worse over the past 2 weeks when he even finds it difficult doing his work as he is always tired. He has also noticed mild gum bleeds after brushing his teeth for the last 2 weeks which stops spontaneously. No had no complaints of rashes, easy bruising, or orifice bleeding otherwise. He does not play sports so has not noticed increased bleeding on contact.
Shamshul used to run 3-4 kms on the treadmill before, but over the past month, he has noticed shortness of breath even after running 2 km and has stopped going to the gym for the past 2-3 weeks.
He has noticed some weight loss which he attributed to not going regularly to the gym lately. He is on normal adult Malaysian diet, takes meat and has not noticed any loss of appetite. No significant gastrointestinal symptoms were reported.
He has been well previously with no previous hospitalisation. However, over the last 2 months, he has been to the general practitioner three times for fever and upper respiratory tract infection symptoms for which he was prescribed antibiotics. The fever usually resolved in 1-2 days.
Shamshul is an accountant who lives in Kuala Lumpur with his parents. He is single, non-smoker, denies drug abuse, not sexually active and is financially independent. Both his parents work in the banking sector.
Physical examination
Shamshul appeared alert, muscular and in good nutritional status and in no acute distress. There was moderate pallor with no jaundice. A few petechial rashes were noted over the chest and lower limbs. No retinal bleeds were observed. Oral examination showed several small white patches on the left buccal mucosa. No oral ulcers or bleeding was noted.


Vital signs showed the following: weight: 64kg, height: 174cm, T: 37.2oC, BP: 110/75mmHg, PR: 72/min, RR: 16/min.
Cardiovascular examination showed normal heart sounds with no murmurs. Breath sounds were normal on lung examination with no crepitations or ronchi.
No palpable masses was detected on abdominal examination. The liver and spleen were not palpable.
No neurological abnormalities were elicited.
Tasks (Part I) – hypothesis generation
- List three possible diagnosis in order of likelihood (principal diagnosis and differential/other diagnosis).
- For each possible diagnosis listed, provide findings from the history and clinical examinations or patient risk factors that would support your diagnosis.
- For each possible diagnosis listed, provide findings opposing the hypothesis, or findings that were expected but not present or elicited during the clinical examination.
- Based on your reasoning above, decide on the first-line laboratory and imaging tests that you would want to perform in the patient. For each test, state how the results may help you to affirm or disprove your hypothesis.
Investigations (first-line)
Haematology & Clinical Chemistry
| Reference range | Units | ||
| Full blood count | |||
| WBC | 1.8 | 4.0 – 11.0 | 109/L |
| RBC | 2.2 | 3.8 – 4.8 | 1012/L |
| Hb | 66 | 120 – 160 | g/L |
| Hct | 0.21 | 0.37 – 0.47 | |
| MCV | 98 | 77 – 97 | fL |
| MCH | 30 | 27 – 32 | pg |
| MCHC | 333 | 315 – 345 | g/L |
| RDW | 13.4 | 11.5 – 15.0 | % |
| Platelet | 64 | 150 – 400 | 109/L |
| Reticulocyte | |||
| Reticulocyte (absolute) | 11.5 | 50 – 150 | 109/L |
| Reticulocyte | 0.52 | 0.5 – 1.5 | % |
| Total white differential counts | |||
| Neutrophils | 0.42 | 2.0 – 7.5 | 109/L |
| Lymphocytes | 1.28 | 1.5 – 4.0 | 109/L |
| Monocytes | 0.1 | 0.2 – 0.8 | 109/L |
| Eosinophils | 0.01 | 0.04 – 0.4 | 109/L |
| Basophils | 0.01 | 0.02 – 0.1 | 109/L |
| Serum electrolytes | |||
| Sodium | 139 | 135 – 148 | mmol/L |
| Potassium | 4.2 | 3.5 – 5.5 | mmol/L |
| Chloride | 98 | 95 – 105 | mmol/L |
| Calcium | 2.5 | 2.1 – 2.7 | mmol/L |
| Magnesium | 0.8 | 0.7 – 1.0 | mmol/L |
| Urea | 3.8 | 2.5 – 6.5 | mmol/L |
| Creatinine | 107 | 45 – 120 | mmol/L |
| Haematinic assays | |||
| Serum vitamin B12 | 576 | 157 – 672 | pmol/L |
| Serum folate | 15.4 | 2 – 20 | pmol/L |
| Serum Iron | 38 | 9.0 – 30.4 | pmol/L |
| Serum transferrin | 3.1 | 2.0 – 3.3 | pmol/L |
| Transferrin saturation | 48 | 20 – 45 | % |
| Ferritin | 387 | 10 – 291 | % |
Tasks (Part II) – information integration and interpretation
- Refine your diagnosis based on the results of the investigation and reprioritise if necessary
- Formulate the next steps in investigation for confirmation of diagnosis, patient assessment prior to treatment initiation and prognostication
Investigations (additional)
Haematology

Microbiology
| HBV DNA | Not detected |
| HCV RNA | Not detected |
| Parvovirus B19 DNA | Not detected |
| HIV RNA | Not detected |
Other investigations
Chest X-ray – normal lung fields, no mediastinal mass noted
Paroxysmal Nocturnal Haemoglobinuria (PNH) studies – no abnormal PNH clone detected in red cells and white cells by flow cytometry
Tasks (Part III) – mechanistic diagram and management
- Develop a mechanistic diagram outlining the scientific mechanisms behind the major signs, symptoms and laboratory results seen in the patient
- Develop a basic care plan for the patient which should address the physical, mental, and social wellbeing needs of the patient